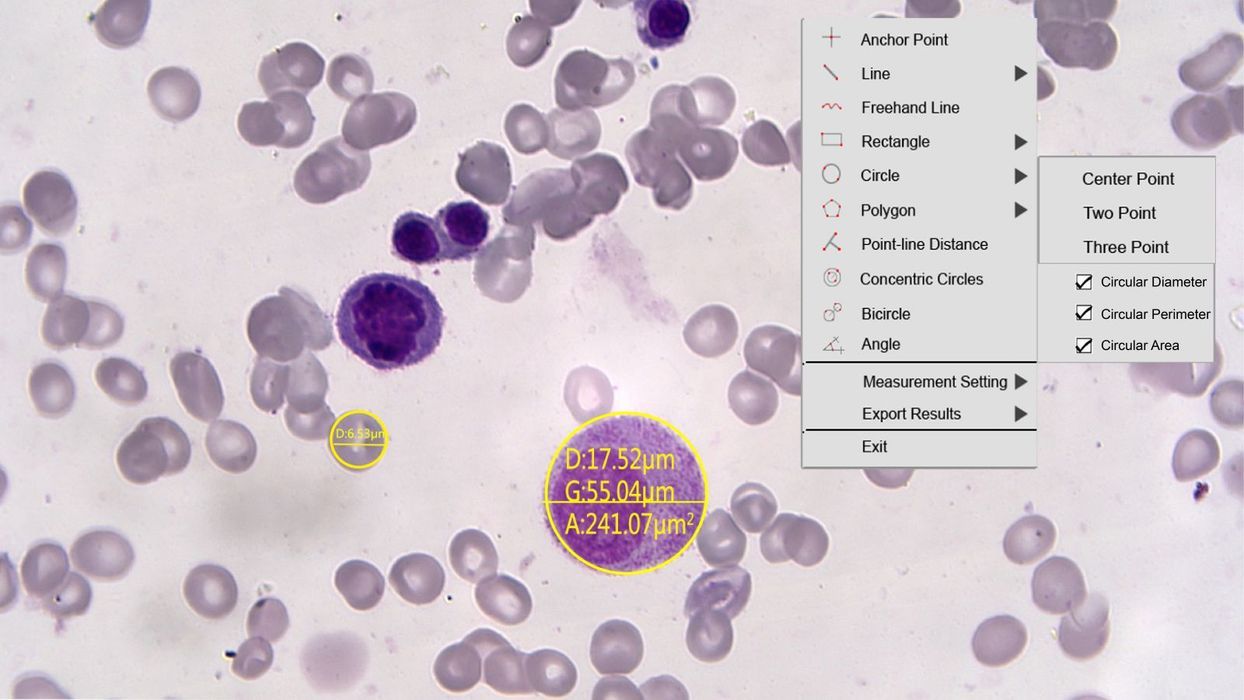

TrueChrome AF - HD Camera
TrueChrome AF - HD Camera with Integrated Digital Image Measurement System & Auto Focusing.
Direct Output to a HD Monitor, No Need for a PC
The TrueChrome AF High Definition colour microscopy camera is a truly remarkable camera for an extensive range of scientific, clinical, educational and industrial applications.
- Outstanding performance and colour reproduction
- 1080p, 60fps – true HD image and motion rendition
- 1080P Video Recording
- 3D Noise Reduction
- Auto Focusing
- Measurement Function
- Accurate colour reproduction at high capture rates
- Direct HDMI output to DVI or HDMI monitor – no computer connection required
- Also computer-connectable via USB 2.0 or HDMI
- Optional output to SD memory card (8GB Included)
- High-speed response means near-instant adjustment to rapid lighting changes and other imaging challenges
- Simple, intuitive controls, for easy image capture, white balance and power adjustment
- Non-compressed data transmission meets the most demanding accuracy requirements
- Suitable applications also include: Pathological Analysis & Fluorescence Imaging
Direct Output to a HD Monitor, No Need for a PC
HD AF offers both continuous and single-shot autofocus modes. It also supports mouse wheel control for fine-tuning. Data transfer up to 60 frames per second enables users to get clear images with ease.
Professional digital image measurement system
HD AF provides extremely powerful measurement functionalities including, freehand line, rectangle, polygon, circle, bicircle, angle, point-line distance and much more. Three different length units of millimeter, centimeter, and micrometer are provided to meet various measurement requirements in different applications.
Mosaic V2.1 Computational Imaging Software
Fast, efficient and worry-free is the core design concept of Mosaic V2.1 software. It adopts a new image "shooting-processing-measurement-reporting" function, modular design, and integrates various intelligent image processing algorithms. It is dedicated to providing users with more simple operation modes and improve work efficiency in all circumstances.
Real-time image stitching
It can generate large-sized mosaic images in a few seconds while moving the stage, which is light, smooth and worry-free!
Perfect colour reproduction
Colour processing is capable of a new level of precision, matches the monitor image to the eyepiece view, produces extremely-high colour definition.
Specifications:
- Sensor: CMOS - SONY IMX307LQR-C
- Sensor Size: 1/2.8"
- Dynamic Resolution: 2MP, 1920x1080
- Static Resolution: 6MP, 3264x1836
- Frame Rate: 60fps @HDMI, 30fps @USB2.0
- Video Recording: 30fps @SD Card, 30fps @PC
- Exposure Mode: Auto/Manual
- Exposure Time: 0.002s-10s
- Output Interface: USB2.0, SD Card, HDMI
- Setting: Gamma,Gain, WDR, Noise Reduction
- White Balance:
- Auto/Manual
- Optical Port: Standard C-Mount
- Built-in Software: Cloud 1.0 Ver
- PC Software: Mosaic 2.1
- Size: 90.7x78x70.8(mm)
- Compatible OS: Windows 7/8/10